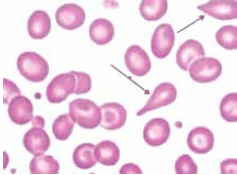
Enunciado 4044233-1

Foram encontradas 1.085 questões.
Na biologia molecular, para avaliar amostras de RNA pela técnica de PCR (Polymerase Chain Reaction), é necessário realizar uma etapa adicional chamada:
Provas
Paciente de 47 anos chega ao pronto atendimento com queixas de dificuldade respiratória, confusão mental e sensação de mal-estar geral. Ao exame físico, apresenta cianose periférica, frequência respiratória aumentada e saturação de oxigênio de 85% no oxímetro. Qual é o exame laboratorial mais indicado para avaliar a condição respiratória e o estado ácido básico desse paciente?
Provas
Analise a imagem.
Material: Esfregaço periférico
(Imagem gentilmente cedida pelo Laboratório de Análises Clínicas do Centro Universitário FMABC)
O esfregaço de sangue venoso revela qual tipo de poiquilocitose sinalizada pelas setas?
Provas
Os testes rápidos padrão para Zika vírus disponíveis no mercado detectam as imunoglobulinas:
Provas
Sobre os manuais de biossegurança nos laboratórios clínicos, a responsabilidade pertence:
Provas
A área da saúde deve sempre se basear em evidências científicas, englobando parâmetros próprios desde a fase pré à pós-analítica. Sobre a utilização do gráfico de Levey-Jennings, permite que o controle de qualidade do laboratório observe
Provas
A determinação de triglicerídeos é uma parte do perfil de lipídeos. Todavia, se o paciente possuir algum tipo de hipercolesterolemia familiar ou erro inato do metabolismo, o sangue coletado mostrará uma alteração que pode ser vista a olho nu, pois essa amostra se encontrará da seguinte forma:
Provas
Criança de 03 anos, em retorno com exames no pediatra pós pneumonia, apresentou um hemograma com laudo de plaquetopenia de 40 000/mm3; o que não condizia com seus exames anteriores e nem sua clínica. Portanto, o médico, avaliando esse cenário, solicitará nova coleta, recomendando coletar 01 tubo de
Provas
A hemoglobina glicada (HbA1c) é um marcador importante no monitoramento do controle glicêmico em pacientes diabéticos. Qual das seguintes afirmações sobre a HbA1c é correta?
Provas
Dentre os granulócitos pode-se citar os basófilos, os eosinófilos e os neutrófilos. Sabe-se que essas células possuem diferentes tipos de grânulos e funções. Grânulos importantes que contribuem de maneira eficaz em nossa resposta imunológica. Esses grânulos se coram densamente quando submetidos à coloração hematológica tradicional. Assinale a alternativa correta que demonstra o tipo de granulócito e a sua função.
Provas
Caderno Container